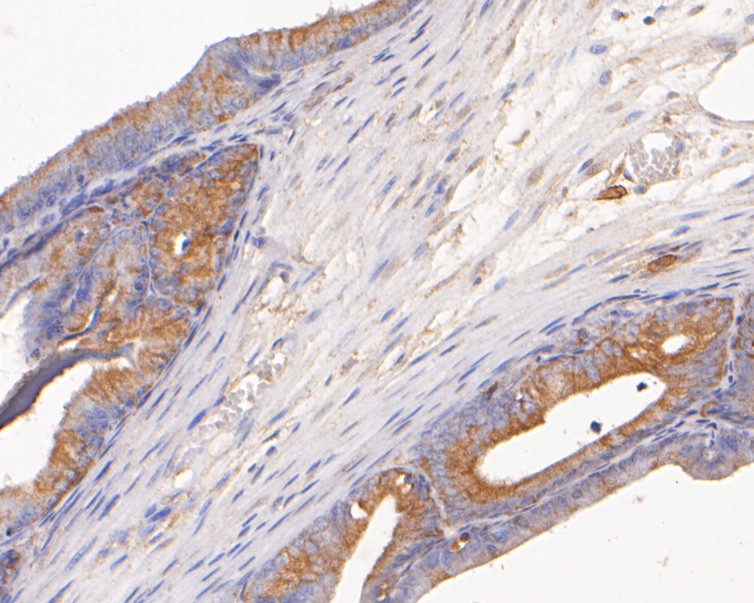

Catalog# ER2001-27
AKR1B1 Rabbit Polyclonal Antibody
Application
-
WB
-
IHC-P
Reactivity
-
Human
-
Rat
Predicted reactivity
 预测的种属支持售后
预测的种属支持售后
-
Mouse